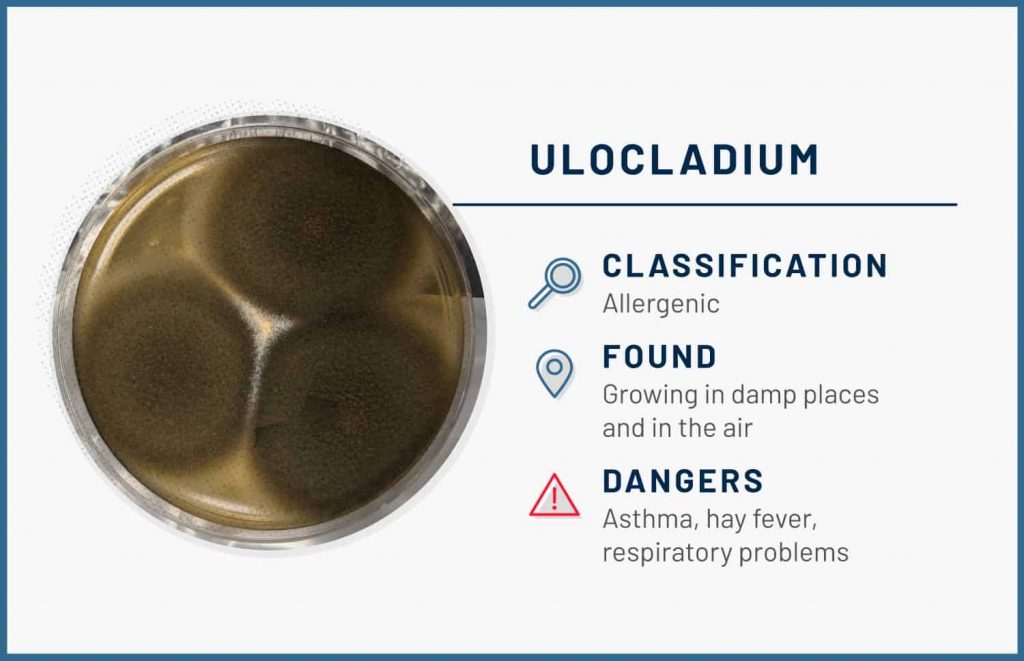
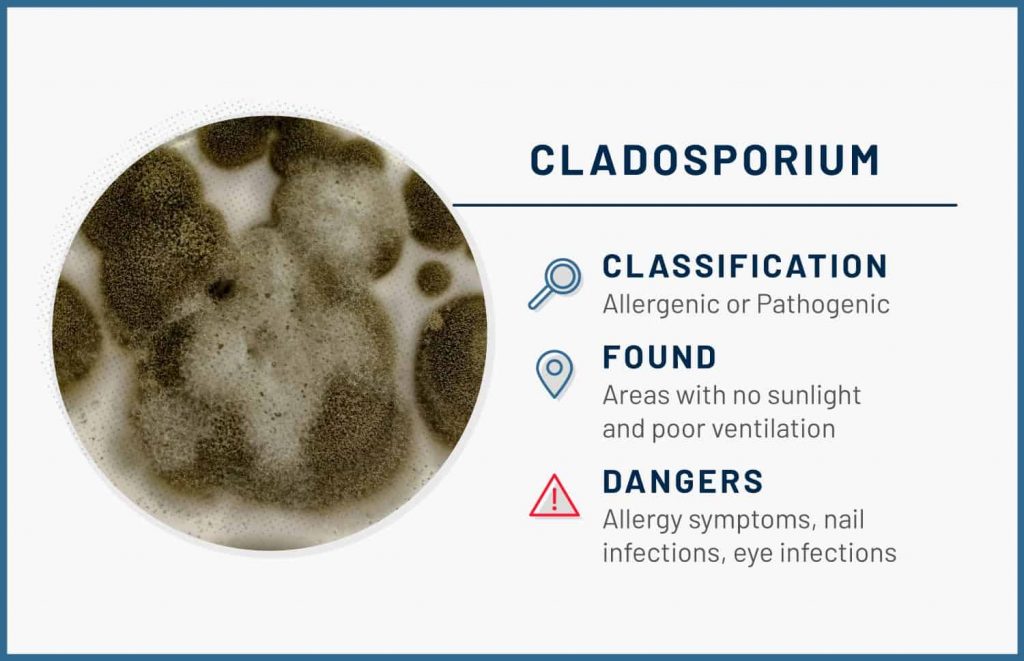
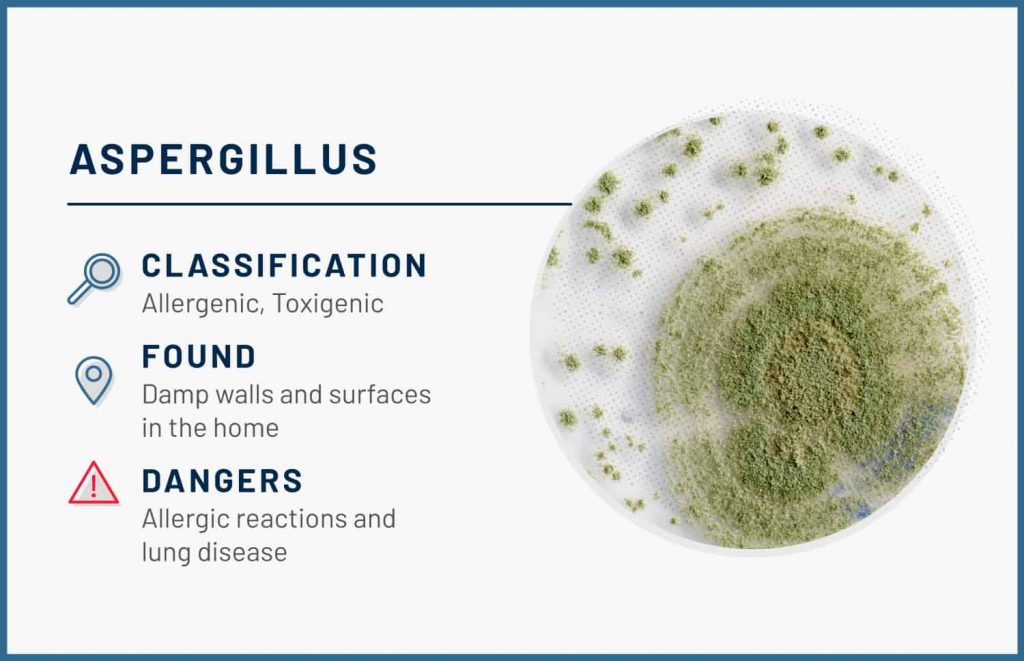

| Aspergillus |
Black, green, or yellow colonies |
HVAC systems, insulation, damp walls, basements |
Asthma flare-ups, allergic reactions, lung infections; some species produce mycotoxins |
| Cladosporium |
Black, brown, or olive-green, suede-like |
Bathrooms, fabrics, HVAC ducts, carpets, wood |
Allergic symptoms (sneezing, itchy eyes, runny nose), asthma attacks; rarely skin or eye infections |
| Penicillium |
Blue, green, or white, velvety |
Water-damaged wallpaper, insulation, mattresses, carpet |
Allergies, asthma, sinus infections; some species produce harmful mycotoxins |
| Stachybotrys (Black Mold) |
Slimy, dark green to black patches |
Water-damaged drywall, ceilings, cardboard, wood, paper |
Chronic coughing, fatigue, headaches, skin irritation; possible neurological effects from mycotoxins |
| Alternaria |
Dark green or brown, fuzzy |
Showers, window frames, sinks, damp basements |
Asthma and allergy trigger; may cause skin rashes and eye infections |
| Chaetomium |
White at first, then gray, brown, or black; cotton-like |
Wet drywall, wallpaper, wood, carpet padding |
Skin and nail infections; some strains produce immune-suppressing mycotoxins |
| Fusarium |
Pink, white, or reddish |
Wet carpets, wallpaper, fabrics, HVAC systems |
Allergic reactions, respiratory irritation, eye or skin infections; some species produce toxins affecting nervous system and liver |